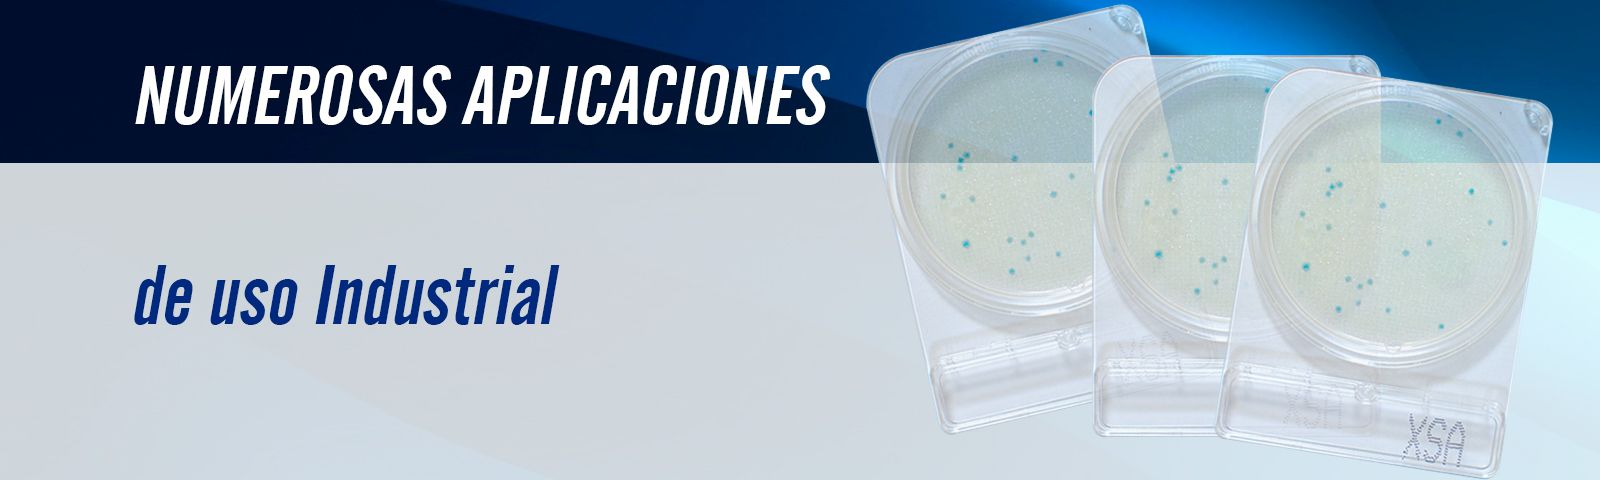

Distribuidora de Tecnología para la Educación SA de CV es una empresa mexicana que mantiene alianzas comerciales para distribuir productos químicos del rubro micro sanitario de fabricantes nacionales y extranjeros. Por lo tanto, las marcas de los productos que comercializamos y distribuimos están registradas o en trámite de registro y son propiedad de sus respectivos dueños.
Distribuidora de Tecnología y sus socios comerciales, preocupados por el monitoreo de microorganismos en los procesos de producción de alimentos, bebidas, cosméticos y medicamentos, ofrecen al mercado nacional la posibilidad de contar con pruebas rápidas para el análisis microbiológico de materia prima, procesos de producción, producto terminado, áreas de almacenamiento y puntos de venta.
Dentro de su portafolio de productos, Distribuidora de Tecnología cuenta con la línea  . Sanitizantes que permiten la limpieza en áreas de trabajo, incluyendo maquinaria y equipo. Detergentes alcalinos y deodorizantes de un paso, detergentes ácidos para residuos minerales y sanitizantes de libre enjuague para manos, entre otros.
. Sanitizantes que permiten la limpieza en áreas de trabajo, incluyendo maquinaria y equipo. Detergentes alcalinos y deodorizantes de un paso, detergentes ácidos para residuos minerales y sanitizantes de libre enjuague para manos, entre otros.
Distribuidora de Tecnología pone a su disposición el Lumitester para la detección de ATP y AMP por bioluminiscencia. Equipo que permite monitorear en forma rápida y sencilla la calidad de la limpieza en las áreas de trabajo permitiendo así que los procesos de producción se lleven a cabo en áreas limpias.
DTE SA de CV, también cuenta con la línea Compact Dry. Pruebas rápidas para el conteo de microorganismos con presentación en placas de estuche semisólido grado cristal estéril con medios de cultivo deshidratados y agentes redox cromógenicos. Tenemos placa para la determinación de mesofilicos aerobios, coliformes totales, E. coli, Salmonella, etc.
Si requiere la detección de proteína alergénica le ofrecemos la línea Clean Do, hisopos de fácil uso y manejo.
Distribuidora de Tecnología cuenta con todo lo necesario para el equipamiento en el laboratorio de análisis de alimentos. Autoclaves, centrifugas, licuadoras, refrigeradores, balanzas, microscopios, mesas de trabajo, sistemas de filtración por membrana, etc.